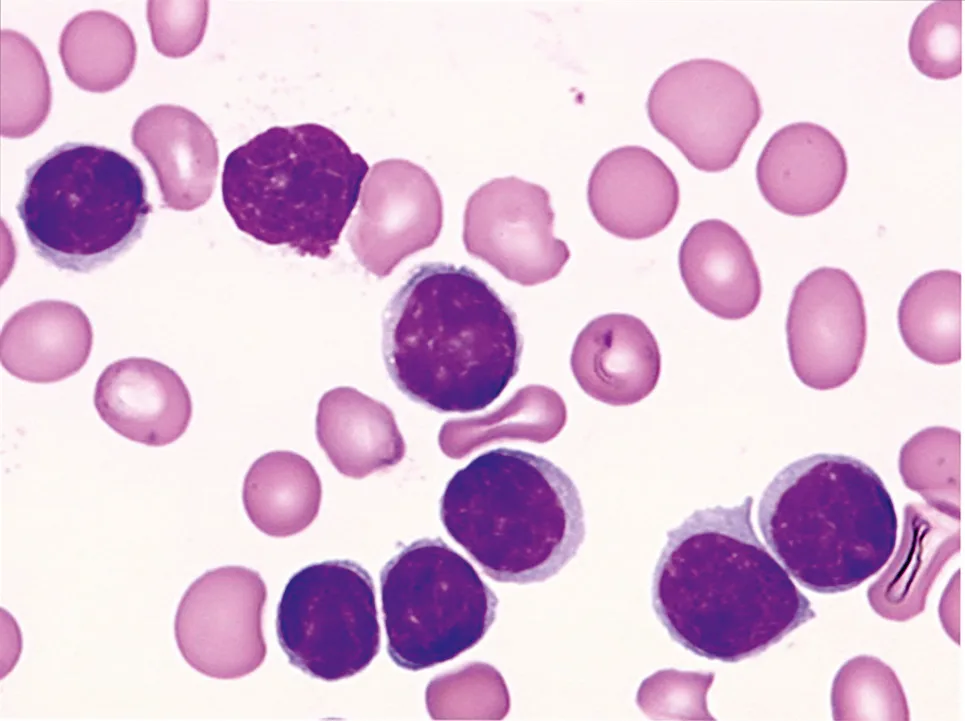

Anatomie et cytologie pathologiques
France | 24 septembre 2019
Par Monique R

Banner - Fig. 33.1
Nous vous proposons de découvrir le chapitre 33 de l'ouvrage Anatomie et cytologie pathologiques S’ouvre dans une nouvelle fenêtre, dans la collection les Référentiels des Collèges.
Item 315 – UE 9 – Leucémies lymphoïdes chroniques
Julien Moroch, Raymond Karkouche, Christiane Copie-Bergman Relecture : Fabien Le Bras, Pierre Sujobert
I. Définition et nosologie II. Épidémiologie III. Présentations et manifestations cliniques IV. Diagnostic V. Syndrome de Richter VI. Diagnostics différentiels
Objectif pédagogique du CoPath
Connaître la place et l’apport de l’anatomie pathologique pour le diagnostic.
I. Définition et nosologie
La leucémie lymphoïde chronique (LLC) est un syndrome lymphoprolifératif B en rapport avec une prolifération clonale de petits lymphocytes B matures avec infiltration de la moelle osseuse, du sang et parfois des ganglions.
Dans la classification de l’OMS 2016, elle est regroupée dans une même entité avec le lymphome lymphocytique B où il y a une atteinte ganglionnaire sans lymphocytose sanguine. Dans le lymphome lymphocytique B, les lymphocytes ont le même phénotype que dans la LLC ; le traitement et le pronostic sont identiques à la LLC.
II. Épidémiologie
Hémopathie maligne la plus fréquente chez l’adulte en Occident, avec une incidence de 3 à 5 pour 100 000 habitants par an en France.
L’âge moyen au diagnostic est d’environ 65 ans.
On note une légère prédominance masculine (sex-ratio H/F = 2/1).
III. Présentations et manifestations cliniques
Cette prolifération tumorale de petits lymphocytes B se manifeste par :
une hyperlymphocytose dans le sang ;
parfois associée à des adénopathies et une splénomégalie (inconstantes) ;
des cytopénies liées à l’infiltration de la moelle hématopoïétique ou à des complications auto-immunes ;
une immunodépression à l’origine d’infections à répétition (hypogammaglobulinémie) ou d’une augmentation de l’incidence des cancers solides (cutanés en particulier).
IV. Diagnostic
A. Formes leucémiques
Diagnostic sur l’hémogramme :
hyperlymphocytose durable supérieure à 5 G/l ;
frottis sanguin montrant de nombreux petits lymphocytes d’aspect mature (fig. 33.1), à la chromatine dense et souvent des « ombres de Gumprecht », qui correspondent à des noyaux nus liés à l’étalement du sang.
Fig. 33.1. Leucémie lymphoïde chronique : frottis sanguin avec des petits lymphocytes à noyaux arrondis, à chromatine dense, et cytoplasme peu abondant (coloration de May-Grünwald-Giemsa × 100).
Le diagnostic de certitude sera porté par l’immunophénotypage lymphocytaire par cytométrie en flux sur le sang périphérique. Cet examen met en évidence une population lymphoïde B exprimant :
les marqueurs B habituels (CD19, CD20) ;
le CD23 ;
le CD5 (habituellement exprimé par les lymphocytes T) ;
et présentant une monotypie, c’est-à-dire exprimant un seul type de chaîne légère (kappa ou lambda) à la surface des cellules.
L’immunophénotypage permet l’établissement d’un score diagnostique allant de 0 à 5 (score de Matutes ou score du Royal Marsden Hospital), qui lorsqu’il est supérieur ou égal à 4 porte le diagnostic de LLC. Un score strictement inférieur à 3 élimine le diagnostic de LLC.
N.B. : dans les lymphocytoses B monoclonales (MBL), on observe des cellules avec des aspects cytologiques et immunophénotypiques comparables aux cellules des LLC mais dont le nombre est inférieur à 5 G/l.
L’analyse cytogénétique par hybridation in situ fluorescente (FISH) est nécessaire si un traitement est envisagé, à la recherche de quatre anomalies récurrentes (del17p, del11q, trisomie 12, del13q), qui ont un impact théranostique (del17p) ou pronostique. Un caryotype conventionnel peut apporter des informations complémentaires.
Pour information, sur le plan moléculaire, la recherche de mutation de TP53 (équivalent fonctionnel de la del17p) a un impact théranostique (indication aux inhibiteurs du BCR en première ligne) et la recherche de mutations des gènes NOTCH1, BIRC3, SF3B1 a un impact pronostique.
Enfin, l’analyse du statut mutationnel du gène codant la chaîne lourde de l’immunoglobuline (IgH) permet de distinguer deux types de LLC, selon que ce gène a subi le processus d’hypermutation somatique (bon pronostique) ou non.
B. Formes non leucémiques
Diagnostic anatomopathologique.
Le diagnostic peut être porté sur une biopsie ostéomédullaire ou sur une biopsie-exérèse de ganglion. Dans les deux cas, le ganglion ou la moelle sont le siège d’une infiltration tumorale d’architecture diffuse, constituée de petits lymphocytes B d’aspect mature et de phénotype CD20+, CD23+, CD5+, CD10−, cycline D1−, avec des zones contenant des cellules de plus grande taille (para-immunoblastes) appelées centres de prolifération.
V. Syndrome de Richter
L’évolution de la LLC se caractérise par la possibilité d’une transformation en lymphome B à grandes cellules (syndrome de Richter).
Il doit être suspecté en cas de :
sueurs nocturnes ;
fièvre au long cours ;
amaigrissement ;
augmentation des LDH ;
apparition d’une adénopathie volumineuse, asymétrique, douloureuse ;
apparition, sur un TEP-scanner, d’un territoire ganglionnaire présentant des SUV max élevées contrastant avec des SUV max faible pour les autres territoires ganglionnaires.
La confirmation diagnostique nécessite une biopsie-exérèse ganglionnaire qui sera adressée à l’état frais au laboratoire d’anatomie pathologie (cf. chapitres 34 et 36).
Une partie du ganglion sera fixée dans du formol pour une analyse morphologique et une étude immunohistochimique. Un autre fragment ganglionnaire sera congelé à l’état frais dans de l’azote liquide, stocké dans un congélateur à – 80 °C, pour d’éventuelles études moléculaires complémentaires (recherche de clonalité lymphocytaire, de translocations récurrentes) (cf. chapitre 34).
Cette procédure permettra la classification précise de ce lymphome selon la dernière classification de l’OMS (2016).
VI. Diagnostics différentiels
Les principaux diagnostics différentiels sont :
les formes leucémiques de certains lymphomes :
lymphome à cellules du manteau,
lymphome de la zone marginale,
lymphome lymphoplasmocytaire ;
la leucémie à tricholeucocyte ;
le lymphome folliculaire pour les formes ganglionnaires de LLC ;
certaines hémopathies lymphoïdes T (leucémie prolymphocytaire T notamment).
Points clés
La LLC correspond à une prolifération tumorale de petits lymphocytes B matures CD20+, CD23+, CD5+, CD10−, cycline D1− supérieure à 5 G/l.
Le diagnostic de LLC repose sur l’immunophénotypage des lymphocytes circulants (cytométrie en flux).
Le diagnostic est anatomopathologique en cas d’absence de passage sanguin des cellules tumorales (lymphome lymphocytique). Il se fera alors sur une biopsie médullaire ou une biopsie-exérèse de ganglion.
Le diagnostic de transformation d’une LLC en lymphome à grandes cellules (syndrome de Richter) est anatomopathologique et nécessite une biopsie-exérèse ganglionnaire à adresser à l’état frais au laboratoire d’anatomie pathologique.
Voici la table des matières de l'ouvrage Anatomie et cytologie pathologiques :
Connaissances I . Notions générales concernant les examens d'anatomie et de cytologie pathologiques intervenant dans la juste prescription II. Pathologie digestive III. Pathologie gynécologique IV. Pathologie urologique V. Néphrologie Amylose Maladie de Horton et vascularites VI. Pathologie thoracique - Pneumologie VII. Tête et cou VIII. Dermatologie IX. Hématologie X. Divers Cancérologie Entraînements
Vous venez de lire le premier chapitre de la partie IX. Hématologie.
Anatomie et cytologie pathologiques Rôle clé dans le diagnostic, l'évaluation pronostique et le traitement CoPath ISBN:9782294758874 A paraître le 2 octobre 2019
En savoir plus S’ouvre dans une nouvelle fenêtre
L'actualité des Référentiels des Collèges et les dernières éditions
Rubrique Études de médecine

Anatomie et cytologie pathologiques